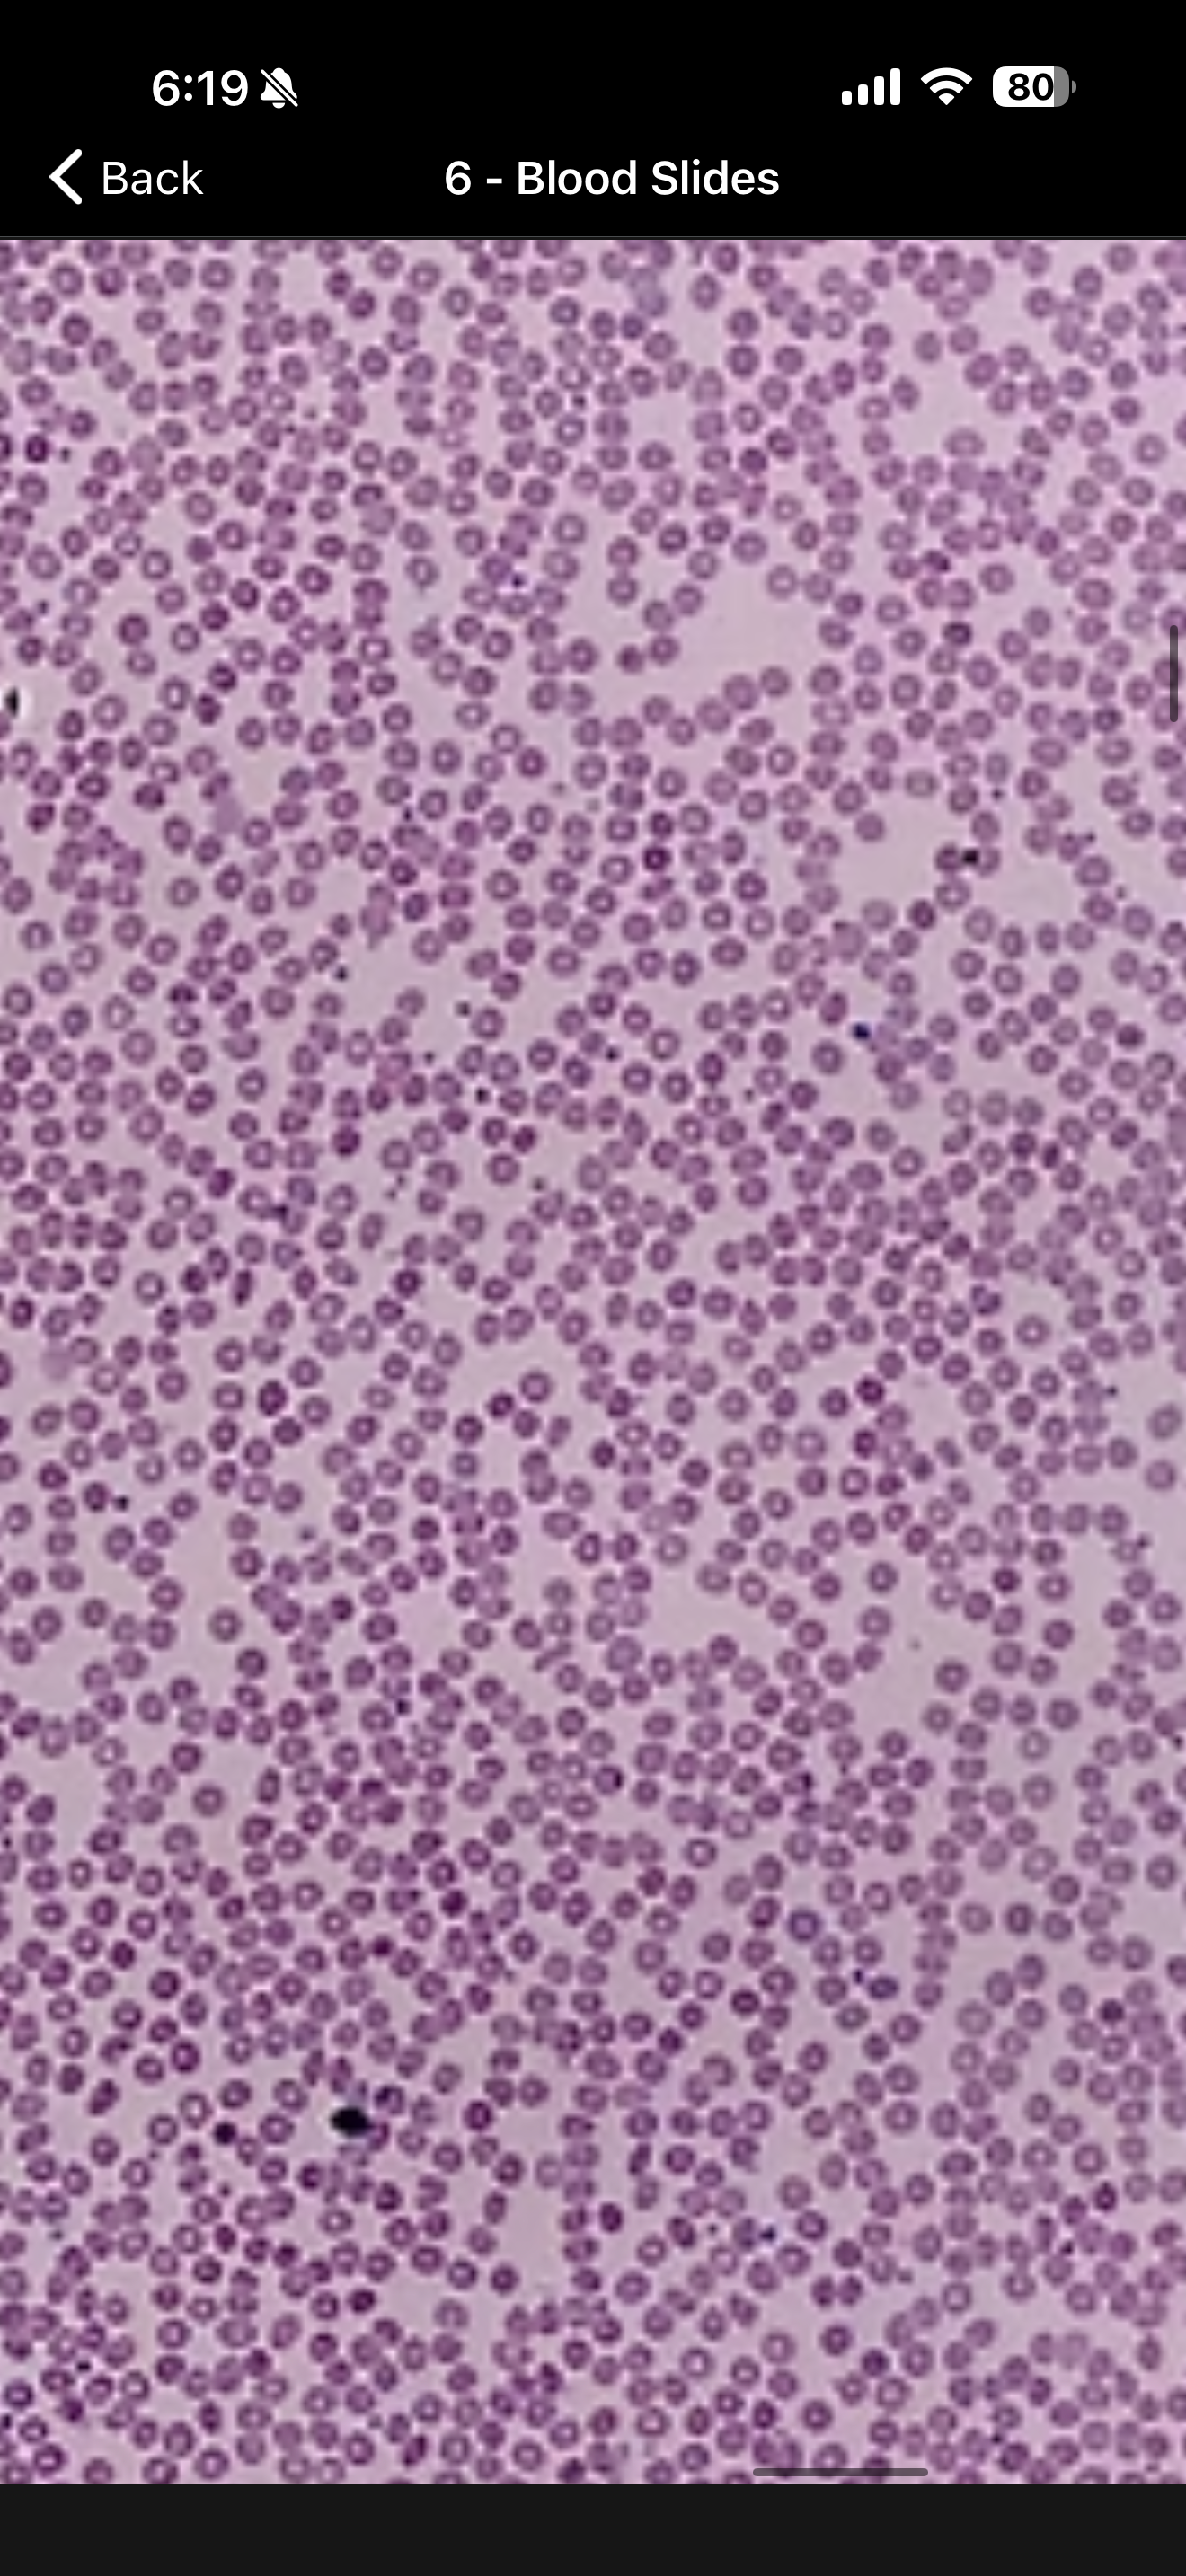
<p><span>red blood cells; mature blood cells that are mostly composed of hemoglobin and functions primarily in the transportation of oxygen and carbon dioxide</span></p>
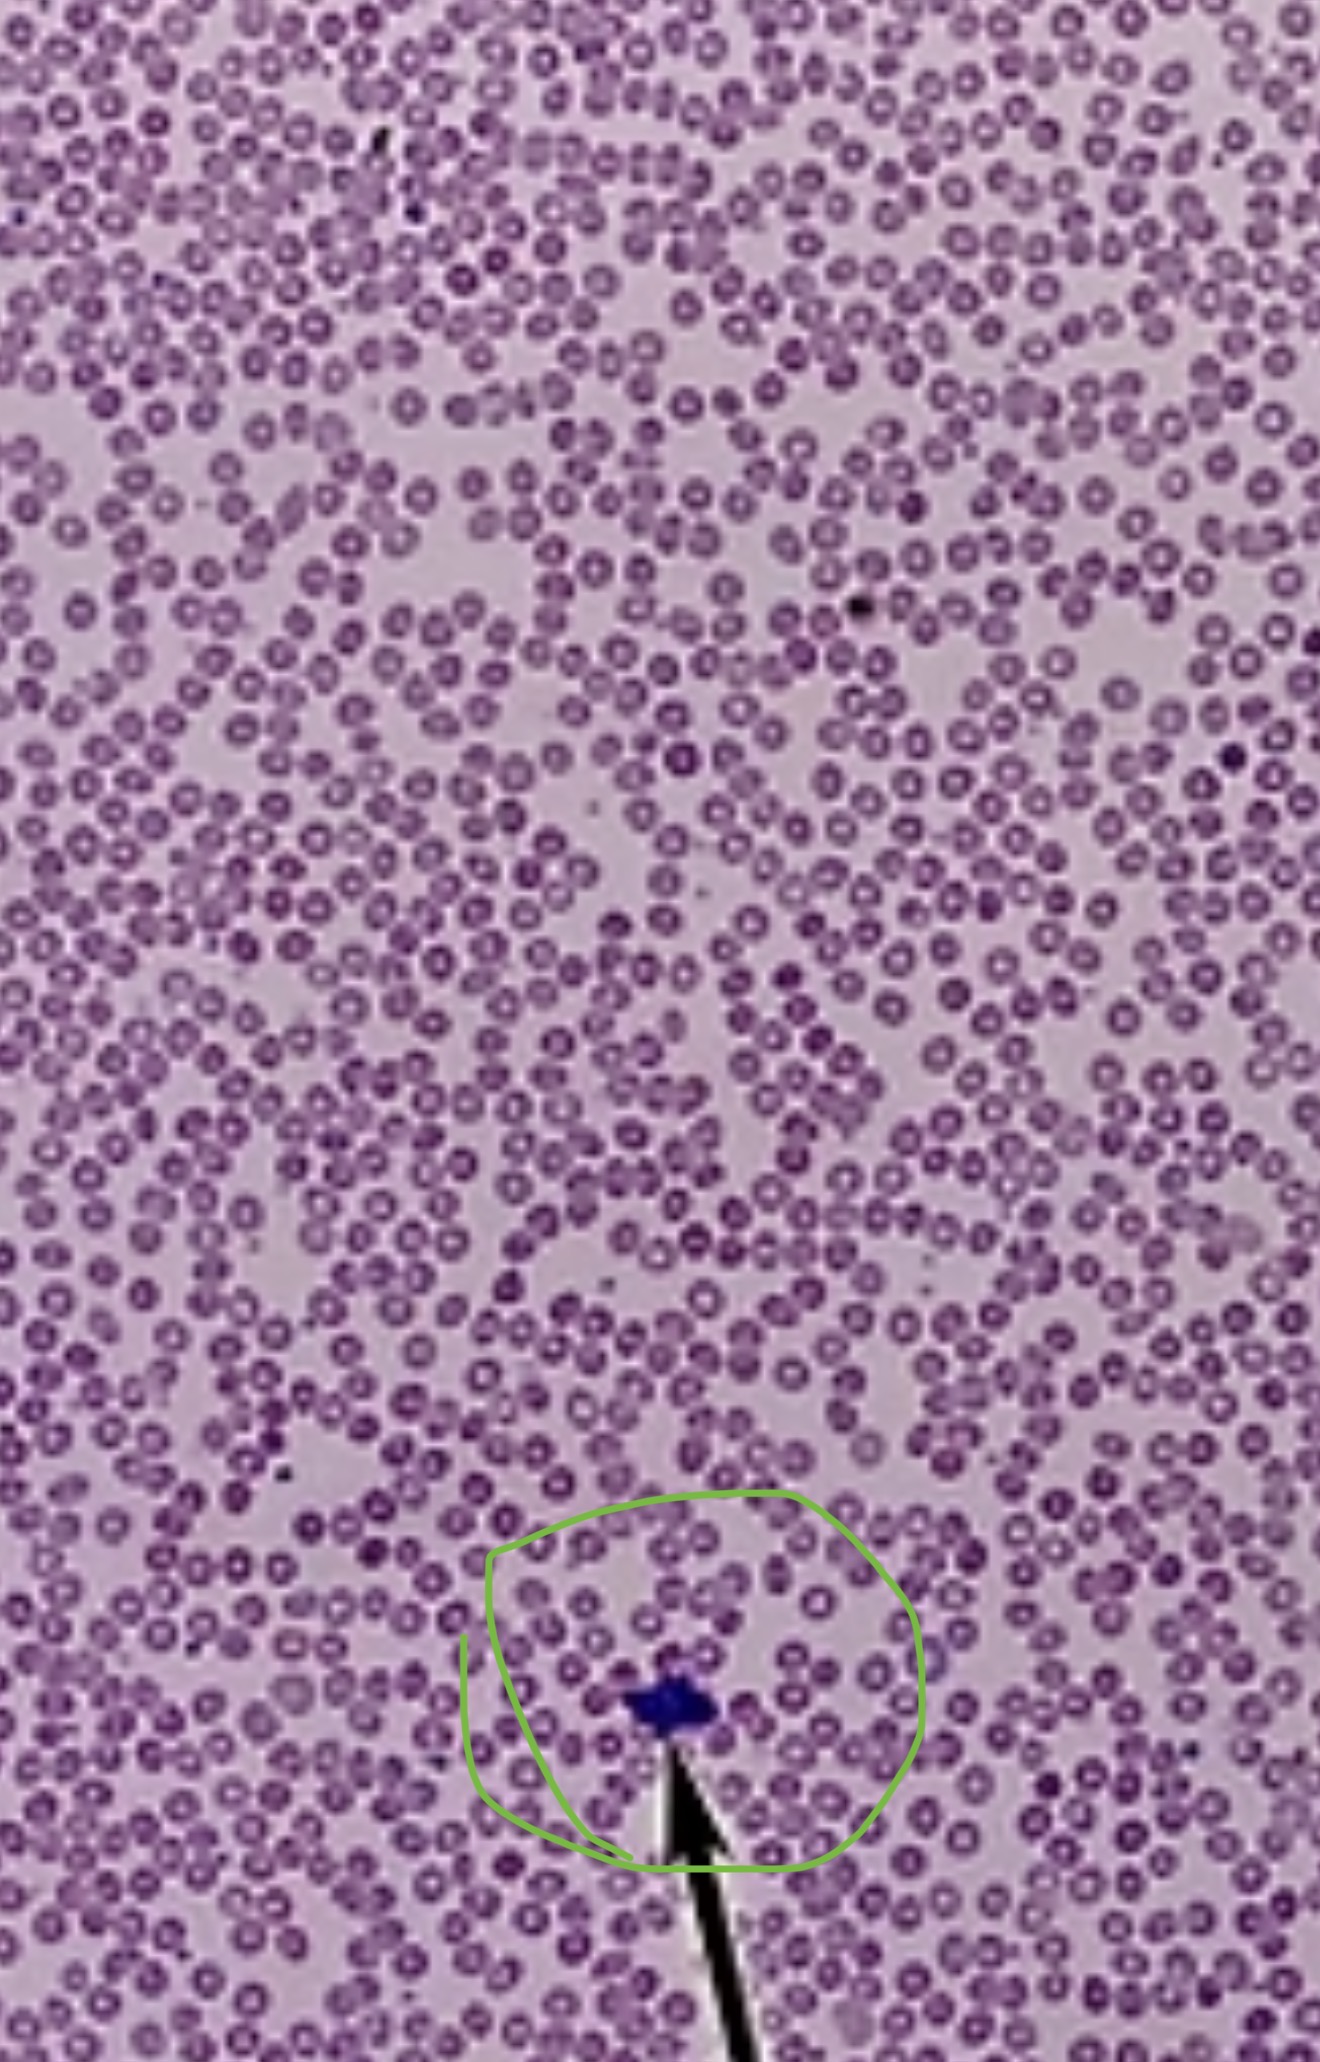
<p><span><span>white blood cells; colorless, nucleated blood cell which protects the body from disease. Contains granulocytes and agranulocytes</span></span></p>
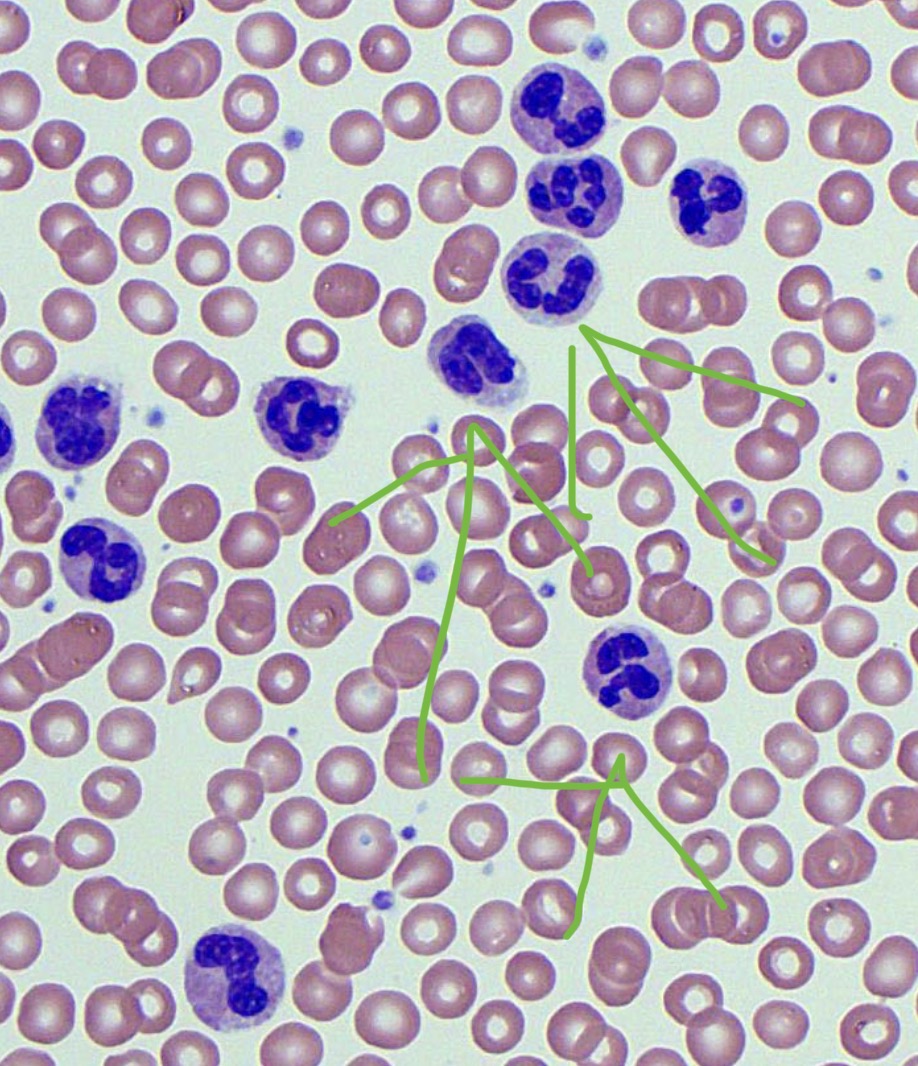
<p>Most common leukocytes, <span>Granules show up the most clearly with stains that are chemically neutral</span></p><p class="s13"><span>○Granules are usually light lilac</span></p><p class="s13"><span>○Nucleus is lobed with 2-5 lobes depending on the age of the cell</span></p><p class="s13"><span>○Rapid responders to infection; phagocytes</span></p><p class="s13"><span>○Granules include lysozymes and other digestive enzymes</span></p>
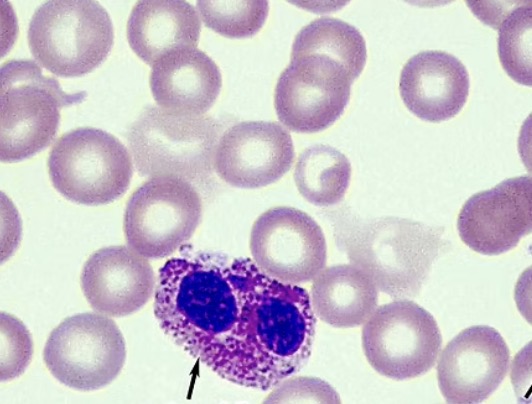
<p><span>less common leukocyte that has a purple nucleus with orange/red cytoplasm</span></p><p class="s13"><span>○Named for the acidic stain eosin</span></p><p class="s13"><span>○Granules are orange to red</span></p><p class="s13"><span>○Nucleus is lobed with 2-3 lobes</span></p><p class="s13"><span>○High eosinophil count is seen with parasitic worms</span></p>
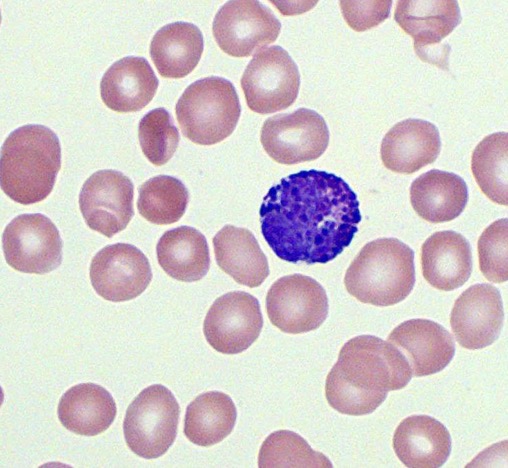
<p><span>even rarer leukocyte with a purple nucleus and large, dark granules</span></p><p class="s13"><span>○Named for the basic stain that works best</span></p><p class="s13"><span>○Granules are large and dark blue and may block out the nucleus.</span></p><p class="s13"><span>Associated with histamines(allergens)</span></p>
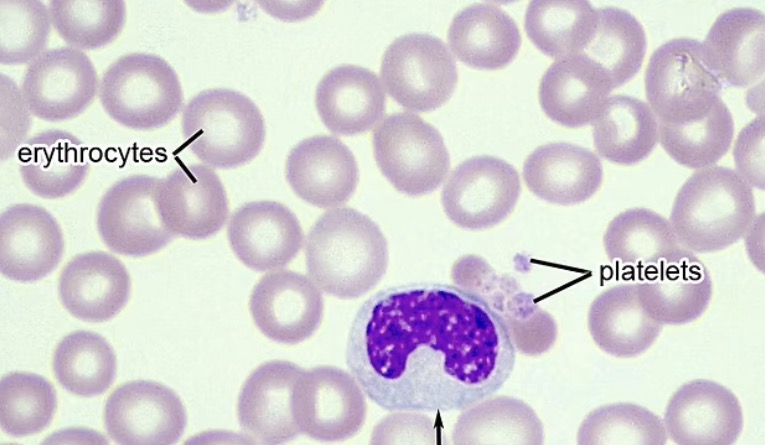
<p><span><span>large horseshoe-shaped nucleus with no granules</span></span></p><p class="s13"><span><span>○Attract other leukocytes</span></span></p><p class="s13"><span><span>○Associated with viral or fungal infections</span></span></p>
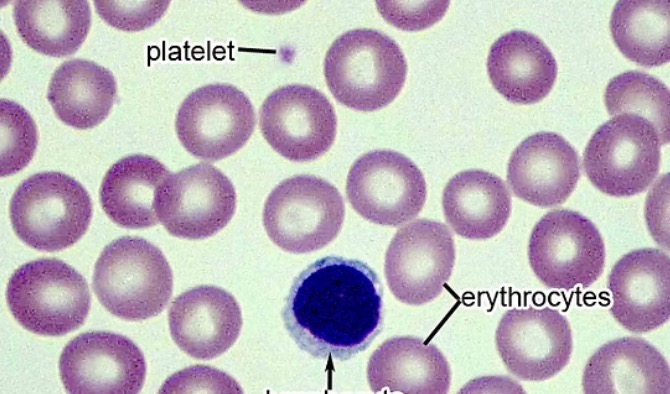
<p><span><span>small white blood cells</span></span></p><p class="s13"><span><span>○About the same size as the surrounding RBCs</span></span></p><p class="s13"><span><span>○Can be B lymphocytes or T lymphocytes but we can’t tell from looking</span></span></p><p class="s13"><span><span>○No granules, Nucleus takes up nearly the entire cell</span></span></p>

A&P unit 3 Lab
1/128
There's no tags or description
Looks like no tags are added yet.
Name | Mastery | Learn | Test | Matching | Spaced | Call with Kai |
|---|
No analytics yet
Send a link to your students to track their progress
129 Terms
Blood
liquid connective tissue made of formed elements and plasma
Plasma
liquid extracellular matrix composed mostly of water that circulates the formed elements. Formed elements - cellular components of blood.
cells in plasma-Erythrocytes (RBCs), Leukocytes (WBCs), Thrombocytes (platelets)
Erythrocytes
red blood cells; mature blood cells that are mostly composed of hemoglobin and functions primarily in the transportation of oxygen and carbon dioxide
Hemoglobin
oxygen-carrying protein complex in erythrocytes
Leukocytes
white blood cells; colorless, nucleated blood cell which protects the body from disease. Contains granulocytes and agranulocytes
neutrophil
Most common leukocytes, Granules show up the most clearly with stains that are chemically neutral
○Granules are usually light lilac
○Nucleus is lobed with 2-5 lobes depending on the age of the cell
○Rapid responders to infection; phagocytes
○Granules include lysozymes and other digestive enzymes
Eosinophil
less common leukocyte that has a purple nucleus with orange/red cytoplasm
○Named for the acidic stain eosin
○Granules are orange to red
○Nucleus is lobed with 2-3 lobes
○High eosinophil count is seen with parasitic worms
Basophils
even rarer leukocyte with a purple nucleus and large, dark granules
○Named for the basic stain that works best
○Granules are large and dark blue and may block out the nucleus.
Associated with histamines(allergens)
Monocyte
large horseshoe-shaped nucleus with no granules
○Attract other leukocytes
○Associated with viral or fungal infections
Lymphocyte
small white blood cells
○About the same size as the surrounding RBCs
○Can be B lymphocytes or T lymphocytes but we can’t tell from looking
○No granules, Nucleus takes up nearly the entire cell
Thrombocyte
fragment of a cell called a megakaryocyte; also known as a platelet
○Very small
○Limit blood loss by contributing to the clotting process
Sickle Cell Amneia
inherited blood disorder in which hemoglobin molecules are malformed, leading to the breakdown of RBCs that take on a characteristic sickle shape

Chronic lymphocytic Leukemia
cancer involving an abundance of leukocytes (leukemia); bone marrow makes too many lymphocytes

Antigens
substances that the body does not recognize as “self” and trigger a defensive response from the immune system
Antibodies
produced by B lymphocytes which attach to specific antigens; has “arms” which can attach to more than one antigen
Agglutination
when antibodies bind to more than one antigen and cause clumping
ABO Blood Group
most important set of antigens in human blood
○Antigens
■A
■B
○Antibodies
■Anti-A
■Anti-B
Rh blood group
second most important antigen in human blood
○Rh positive
○Rh negative
Closed circulatory system
blood is always contained within blood vessels
Artery
blood vessel that conducts blood away from the heart (Red)
Capillary
small blood vessel where gas exchange occurs between the blood and tissues
Vein
blood vessel that brings blood back to the heart (Blue)
Pulmonary circuit
moves blood from the right side of the heart to the lungs and back to the left side of the heart; begins with oxygen poor blood and ends with oxygen rich blood
Systemic circuit
moves blood from the left side of the heart to the head and body and returns to the right side of the heart; begins with oxygen rich blood and ends with oxygen poor blood
Tunica intima
innermost lining of a vessel. Endothelium, Internal elastic lamina

Endothelium
specialized simple squamous epithelium
Internal elastic lamina
Thick layer of elastic fibers*

Tunica media
middle layer of a vessel (except capillaries)
○Thickest layer in arteries
○Much thicker in arteries than veins
○Layers of smooth muscle

Tunica Externa
outermost layer (except capillaries)
○Sheath of connective tissue that holds the vessel in place

Valves
present in larger veins that promote the unidirectional flow of blood toward the heart and prevent backflow toward the capillaries
Atherosclerosis
a buildup of plaque – fatty material including cholesterol, connective tissue, and white blood cells – which causes a hardening of the arteries
Aorta
Largest artery in the body, originating from the left ventricle and descending to the abdominal region

Aortic arch
arch connecting ascending to descending aorta

Brachiocephalic Trunk
Single vessel located on the right side of the body; the first vessel branching from the aortic arch; gives rise to the right subclavian artery and the right common carotid artery

Axillary
continuation of the subclavian artery as it penetrates the body wall and enters the axillary region; becomes the brachial artery

Brachial
continuation of the axillary artery; bifurcates into the radial and ulnar arteries

Ulnar
Parralels the ulna

Radial
Parallels the radius

Intercostal
branch of the thoracic aorta; supplies blood to the muscles of the thoracic cavity and vertebral column

Celliac trunk artery
major branch of the abdominal aorta; gives rise to the left gastric artery, the splenic artery, and the common hepatic artery

Hepatic artery
a blood vessel located in the upper abdomen that carries oxygen-rich blood from the heart to the liver, running from the aorta (through the celiac trunk) toward the liver where it supplies the oxygen needed for proper liver function.

Superior mesenteric Artery
branch of the abdominal aorta; supplies blood to the small intestine

Renal Artery
branch of the abdominal aorta; supplies each kidney

Gonadal
branch of the abdominal aorta; supplies blood to the gonads

Inferior Mesenteric Artery
a blood vessel located in the lower abdomen that branches off the aorta and supplies oxygen-rich blood to the descending colon, sigmoid colon, and part of the rectum.

Common Iliac artery
branch of the aorta that leads to the internal and external iliac arteries

Internal iliac artery
supplies blood to the urinary bladder, walls of the pelvis, external genitalia, and the medial portion of the femoral region
External iliac artery
becomes a femoral artery; supplies blood to the lower limbs

Femoral artery
a large blood vessel located in the upper thigh that continues from the external iliac artery and supplies oxygen-rich blood to the thigh, leg, and foot.

Popiteal artery
a continuation of the femoral artery that runs behind the knee through the popliteal region. It supplies blood to the knee joint, surrounding muscles, and lower leg, and eventually branches into the anterior and posterior tibial arteries.

Anterior tibial artery
a branch of the popliteal artery that passes through the interosseous membrane to the front of the lower leg. It supplies oxygenated blood to the anterior (front) compartment muscles of the leg and continues down to become the dorsalis pedis artery on the top of the foot.

Posterior tibial artery
a branch of the popliteal artery that travels down the back of the lower leg. It supplies blood to the posterior muscles of the leg and passes behind the medial malleolus (inner ankle) before branching into arteries that supply the bottom of the foot.

Anterior tibial vein
a deep vein that runs alongside the anterior tibial artery in the front of the lower leg. It drains deoxygenated blood from the anterior compartment of the leg and carries it upward to join the popliteal vein behind the knee.

Small saphenous vein
a superficial vein that runs along the back of the lower leg, starting from the lateral side of the foot and traveling upward. It drains deoxygenated blood from the surface of the foot and posterior leg, and typically empties into the popliteal vein behind the knee.

Popiteal vein
a deep vein located behind the knee that forms from the union of veins such as the anterior tibial vein and posterior tibial vein. It carries deoxygenated blood from the lower leg and continues upward to become the femoral vein.

Great saphenous vein
the longest superficial vein in the body, running from the medial side of the foot up along the inner leg and thigh. It drains deoxygenated blood from the superficial tissues of the lower limb and empties into the femoral vein near the groin.

Femoral vein
a large deep vein in the thigh that continues from the popliteal vein and travels upward through the thigh. It drains deoxygenated blood from the lower limb and eventually becomes the external iliac vein as it passes into the pelvis.

External iliac vein
a large vein in the pelvis that continues from the femoral vein as it passes under the inguinal ligament. It carries deoxygenated blood from the lower limb and joins with the internal iliac vein to form the common iliac vein.

Internal iliac vein
a vein in the pelvis that drains deoxygenated blood from the pelvic organs, gluteal region, and perineum. It joins with the external iliac vein to form the common iliac vein.

Common iliac vein
formed by the joining of the external iliac vein and internal iliac vein on each side of the body. It carries deoxygenated blood from the pelvis and lower limbs and drains into the inferior vena cava.

Gonadal vein
drains deoxygenated blood from the gonads (testes in males, ovaries in females). On the right side, it usually empties directly into the inferior vena cava, while on the left side, it typically drains into the left renal vein.

Renal vein
a large vein that drains deoxygenated blood from the kidneys. The right and left renal veins carry blood from their respective kidneys and empty into the inferior vena cava.

Inferior Vena cava
the largest vein in the body that carries deoxygenated blood from the lower limbs, pelvis, and abdomen back to the heart. It runs along the right side of the vertebral column and empties directly into the right atrium.

Hepatic vein
veins that drain deoxygenated blood from the liver. They collect blood from the liver sinusoids and empty directly into the inferior vena cava just below the diaphragm.

Ulnar vein
a deep vein of the forearm that runs alongside the ulnar artery on the medial (pinky) side of the forearm. It drains deoxygenated blood from the hand and forearm and typically joins with the radial vein to form the brachial vein.

Radial vein
a deep vein in the forearm that runs alongside the radial artery on the lateral (thumb) side of the forearm. It drains deoxygenated blood from the hand and forearm and usually joins the ulnar vein to form the brachial vein.

Brachial vein
is a deep vein of the upper arm that is formed by the union of the radial vein and ulnar vein. It runs alongside the brachial artery and drains into the axillary vein.

Basilic vein
a superficial vein of the medial (inner) side of the upper limb. It drains deoxygenated blood from the hand and forearm and eventually joins the brachial vein to help form the axillary vein.

Cephalic vein
a superficial vein that runs along the lateral (thumb) side of the upper limb. It drains deoxygenated blood from the hand and forearm and empties into the axillary vein near the shoulder.

Axillary vein
is a large vein in the armpit (axilla) that is formed by the union of the brachial vein and the basilic vein. It drains deoxygenated blood from the upper limb and continues upward to become the subclavian vein.

Subclavian vein
a large vein that runs under the clavicle (collarbone) and continues from the axillary vein. It drains deoxygenated blood from the upper limb and joins the internal jugular vein to form the brachiocephalic vein.

External jugular vein
a superficial vein in the neck that drains deoxygenated blood from the scalp, face, and superficial regions of the neck. It runs down the lateral side of the neck and empties into the subclavian vein.

Internal jugular vein
a major vein in the neck that drains deoxygenated blood from the brain, face, and neck. It runs alongside the common carotid artery and empties into the brachiocephalic vein.

Brachiocephalic vein
formed by the union of the internal jugular vein and subclavian vein on each side. It drains deoxygenated blood from the head, neck, and upper limbs into the superior vena cava.

Superior vena cava
a large vein that carries deoxygenated blood from the head, neck, upper limbs, and upper thorax back to the heart. It empties directly into the right atrium.

Azygos vein
is a vein along the right side of the vertebral column in the thorax that drains deoxygenated blood from the thoracic wall and some abdominal structures. It arches over the right lung’s root and empties into the superior vena cava.

Branches of the aortic arch
Brachiocephalic trunk → splits into:
Right subclavian → right upper limb
Right common carotid → right head & neck
Left common carotid → left head & neck
Left subclavian → left upper limb

Which two veins drain into the superior vena cava?
Left and right brachiocephalic veins – each formed by the union of the internal jugular vein and subclavian vein on its side.
This drains from head, neck and upper limbs
Which veins drain into the inferior vena cava?
receives deoxygenated blood from veins that drain the lower body, including:
Common iliac veins – from the pelvis and lower limbs (formed by the external and internal iliac veins).
Renal veins – from the kidneys.
Hepatic veins – from the liver.
Gonadal veins – from the testes or ovaries (right drains directly to IVC; left usually drains into left renal vein).
Lumbar veins – from the posterior abdominal wall.
Phrenic veins – from the diaphragm.
Two branches of brachiocephalic trunk
Right Common Carotid Artery: Supplies the right side of the head and neck.
Right Subclavian Artery: Supplies the right upper limb and provides the right vertebral artery for brain circulation
.
Two veins that drain into the common iliac vein?
External iliac vein – drains the lower limb.
Internal iliac vein – drains the pelvis, gluteal region, and perineum.
Two branches of the popiteal artery?
Anterior tibial artery – passes to the front of the lower leg and supplies the anterior compartment of the leg and the dorsum (top) of the foot.
Posterior tibial artery – runs down the back of the lower leg, supplying the posterior compartment of the leg and the plantar surface (bottom) of the foot.
Pericardium
double-layered sac around the heart; fibrous layer anchors the heart, serous layer (parietal + visceral/epicardium) lines heart and reduces friction with pericardial fluid.

Parietal pericardium
outer layer of the serous pericardium that lines the fibrous pericardium and helps form the pericardial cavity.

Visceral pericardium
inner layer of the serous pericardium that directly covers the surface of the heart and forms part of the pericardial cavity.

Pericardial cavity
space between the parietal and visceral layers of the serous pericardium that contains lubricating fluid to reduce friction as the heart beats.

Superior vena cava (Heart)
on a heart model is the large vein entering the right atrium from above. It carries deoxygenated blood from the head, neck, upper limbs, and upper thorax into the heart. On most models, it’s positioned on the anterior/superior right side of the heart.

Inferior vena cava (heart)
on a heart model is the large vein entering the right atrium from below. It carries deoxygenated blood from the lower limbs, pelvis, and abdomen into the heart. On models, it’s usually shown at the posterior/inferior right side of the heart.

Right atrium
the heart chamber that receives deoxygenated blood from the superior and inferior vena cavae and the coronary sinus, then passes it to the right ventricle through the tricuspid valve.

Pectinate muscles
parallel ridges of muscle found on the anterior wall of the atria (mostly the right atrium) that help increase the force of atrial contraction without greatly increasing heart mass

Tricuspid valve
valve between the right atrium and right ventricle that prevents backflow of blood into the atrium when the ventricle contracts.

Right ventricle
heart chamber that receives deoxygenated blood from the right atrium and pumps it through the pulmonary valve into the pulmonary artery toward the lungs.

Cusps of the tricuspid valve in right ventricle

Chordae tendinae
thin, strong cords that connect the atrioventricular (tricuspid and mitral) valve leaflets to the papillary muscles, preventing valve prolapse during ventricular contraction.

Papillary muscles
cone-shaped muscles in the ventricles that attach to the chordae tendineae and contract to prevent atrioventricular valves from inverting during ventricular contraction.

Pulmonary trunk
large artery that carries deoxygenated blood from the right ventricle to the pulmonary arteries for transport to the lungs.

Pulmonary semilunar valve
valve between the right ventricle and pulmonary trunk that prevents backflow of blood into the ventricle after contraction.

Pulmonary arteries
blood vessels that carry deoxygenated blood from the right ventricle through the pulmonary trunk to the lungs for oxygenation.

Interventricular septum
Seperating tissues between ventricles

Pulmonary veins
vessels that carry oxygenated blood from the lungs to the left atrium of the heart.
